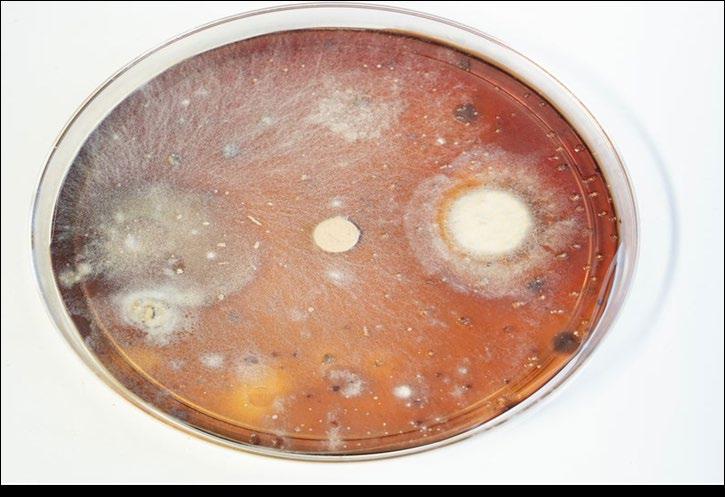

![]()



Help your teams build practical skills and cloud expertise critical to your organization. Over 600 digital courses and curated learning plans, along with interactive, hands-on training, provide engaging learning experiences that span more than 30 technical domains and all skill levels.
Build cloud skills at scale with AWS Skill Builder, the online learning center built by AWS experts
• Self-paced labs with AWS Builder Labs
• Expert AWS instructor-led training - on demand with AWS Digital Classroom
• Game-based learning with AWS Cloud Quest and AWS Industry Quest
• Use case challenges with AWS Jam
• Exam preparation for AWS Certification
Top 5 benefits of AWS Skill Builder for Teams
1. Accelerate business transformation
2. Encourage hands-on experience
3. Develop expertise in key roles and industries
4. Motivate teams with collaborative learning and friendly competition
5. Fast-track career development for team members

eBook: Build Cloud Expertise and Transform Your Business
Discover how empowering your teams with cloud skills can drive innovation.

Learn how to maximize your cloud investment by upskilling your workforce with diverse training and learning experiences.
Download the eBook › Watch the demo ›
We’re not authors, but we help our clients shape their businesses’ financial stories.
We’re not architects, but we help our clients build stronger businesses.
We’re not an airline, but our network connects global businesses in nearly 180 local markets.

but we help our clients digitally transform their businesses.
Consumer
Healthcare in Transition: Building Sustainable Growth in Thailand’s Medical Industry Thailand’s Updated Alcohol Law Balances
Tightens Import Controls on Health Products Through Customs Database Integration
Connected Markets: FTAs and the Future of
Meet the Board Candidates
Working Meeting on Thailand's Digital Regulatory Development
Tariffs and the Future of Healthcare in Thailand
Recognizing Discrimination and Transforming the Thai Workplace
Legal Updates & Networking
Governors' Table @ The St. Regis
Navigating Price Pressures: Automotive Cost Strategies in a Shifting Tariff
EEC Networking
Cargill Is Reducing Food Waste, One Innovation at a Time
BURI GROUP and Bio Buddy Launch Minor Food Aims for 4,500 Outlets by 2029
MedPark Hospital Launches Hair Restoration Center
NIST Class of 2025 Soars with Record IB Results and Global University Destinations
Embassy Room La Marina Refines Its Coastal Italian Identity with New Chef Alessio Banchero
Cathay Pacific Returns to Seattle with Five Non-Stop Return Flights Per Week
Welcome New Members

From platforms that screen over half of the world’s blood supply, to wearable sensors that track glucose levels without blood, life-changing technology from Abbott helps people live healthier, fuller lives.
DIAGNOSTICS | MEDICAL DEVICES | NUTRITION | PHARMACEUTICALS

AMCHAM BOARD OF GOVERNORS 2025
PRESIDENT
Chatit Huayhongtong, Chevron
VICE PRESIDENTS
Wiyada Srinaganand, 3M Thailand
Ornkanya (Mook) Pibuldham, Bank of America N.A.
Peerasak Gamonsugosol, Honeywell Systems
Sondra Sutton Phung, Ford Motor Company
TREASURER
Simon Denye, Harmless Harvest
SECRETARY
Ririnda Tangtatswas, Minor International
GOVERNORS
Narumon Chivangkur, Citibank
Raymond Deidrick, Ingredion
Winnie Wong, Mastercard
Asama (Prae) Dumrongmongcolgul, Meta
Mark Kuo, Pfizer Thailand
Norachet Saetang, Seagate Technology
John Evans, Tractus
Philip Bernard, Western Digital
EXECUTIVE DIRECTOR
Heidi Gallant
T-AB Magazine is a publication by The American Chamber of
101 True Digital Park, Griffin Building, Level 12A, Unit No.12A-06, Sukhumvit Road, Bangchak, Phra Khanong, Bangkok 10260 Tel: +66 (0)2 119 3350 www.amchamthailand.com
Editorial Advisory Board: Heidi Gallant
Editors: Varsha Wadhwani Phenphitchaya Chapanon
Any opinions expressed in articles in this magazine do not necessarily reflect the views of the Chamber.
T-AB Magazine welcomes contributions from AMCHAM members. Articles may be reproduced with acknowledgement, except those taken from other sources.
Dear Members,
AMCHAM is delighted to share the AMCHAM Thailand Foundation’s scholarship recipients for 2025. Please click this link to see the students joining our program

and those continuing their studies with our support.
The new scholarship students will come to Bangkok in January 2026 for their orientation camp and next year’s graduating class will visit us for their career camp in June 2026.
The 117 university and vocational scholarships we are providing this year would not be possible without the generous support of AMCHAM members. On behalf of AMCHAM and the AMCHAM Thailand Foundation (ATF), I would like to thank everyone who has supported our fundraising events, donated directly to the ATF and contributed time and expertise to these programs. If you are interested in learning more about AMCHAM’s charity arm, please attend our Community Projects Council meeting on October 24.

Sincerely, Sincerely,
Heidi Gallant Executive Director











































By Julie Sawyer Montgomery, Danaher

Imagine a world where screening for Alzheimer's disease is as routine as a colonoscopy or mammogram. Far from being a dreaded test that confirms an inevitable decline, it is an empowering tool – one that gives patients knowledge so they can act when their actions can have the greatest impact on their future health.
This is not a far-off dream. It is the future we are working to create.
Our cultural understanding of aging assumes cognitive decline is a foregone conclusion. We see our loved ones showing early symptoms, forgetting names, misplacing items, struggling with familiar tasks—and we resign ourselves to what seems like the natural course of events.

This belief runs deep. A 2024 survey reported in the World Alzheimer Report found that 65% of health care professionals and 80% of the general public believe dementia is a normal part of aging. While mild cognitive changes like slower processing speed or occasional forgetfulness are considered normal, dementia and more severe cognitive decline are not.
For too long, we have accepted cognitive decline as an indignity of aging. There is another option: to approach cognitive changes with the same investigation, education, and intervention we bring to other health concerns. When it comes to Alzheimer's disease, acting early – including early diagnosis and treatment – can significantly impact disease progression and quality of life.
The treatment landscape for Alzheimer’s is widening dramatically. Where previously we were limited to unproven lifestyle interventions like diet, exercise, and intellectual stimulation, we now have targeted treatments.
Every day, our disease-fighting capabilities more closely resemble precision oncology. The therapeutic pipeline is expanding to cover a wider variety of targets, creating a library of options
to treat more kinds of disease with greater precision. AI-driven insights are deepening our understanding of Alzheimer’s biology, setting the stage for even more targeted therapeutic options in the coming years.
Targeted therapeutics need diagnostics that can match their precision. A true precision diagnosis will not only prompt therapeutic intervention— it will also point us toward the right kind of therapy for each unique patient, monitor how well the therapy is working and how long patients need to stay on the treatment to see results. Precision diagnostics can also speed the development of new precision drugs, just as has been the case in oncology.
Like many cancer drugs, these new medications are not easy drugs to take. The more we can help patients get the right treatment at the right moment, the better poised we are to help make their lives meaningfully better.
At the heart of this paradigm shift in testing for Alzheimer's is accessibility. Even the most transformative diagnostic tools cannot help patients if they are only available in specialized centers, require complex procedures, or come with prohibitive costs. Alzheimer's diagnostics must meet patients where they are—in their regular lives and where they get their regular medical care.
That is why our industry is investing heavily in developing non-invasive, blood-based tests for complex neurodegenerative diseases. Recent breakthroughs—like Beckman Coulter's blood test receiving FDA Breakthrough Device designation and the Washington UniversityBeacon collaboration—suggest we are on the cusp of making this vision reality.
These advancements are not just scientifically significant; they are transformative for patients. They promise testing that is less invasive, more affordable, and capable of earlier detection when interventions can make the greatest impact.
Perhaps most powerfully, an accessible bloodbased test will help erase the stigma that often
accompanies cognitive assessments. Just as we have normalized other health screenings by emphasizing their life-saving potential, a routine and accessible Alzheimer’s test can become a simple and critical information-gathering step.
When diagnostic innovation prioritizes patients considering their experience, their access, and their agency, we create tools that truly serve human health. The more knowledge patients and families have, the easier it will be for them to take steps to proactively delay the disease onset and maximize symptom-free or symptommanaged years.
By putting patients and their families first as we innovate precision diagnostics, we can begin to change the narrative around Alzheimer's from one of inevitable decline to one of empowered choices and hopeful possibilities.


Julie Sawyer Montgomery is the Executive Vice President of Danaher Diagnostics Platform. Julie brings a track record of challenging the status quo to drive strategic business growth and innovation.
By Raymond Deidrick, Ingredion Incorporated

Grocery shopping decisions are evolving. Ingredion’s latest research highlights key trends in health, clean label claims, and generational preferences shaping the future of food and beverages.
Staying ahead of consumer preferences is no easy task for food and beverage brands. Tastes, health priorities, and ethical values change over time, and what mattered to shoppers a few years ago may no longer resonate.
Ingredion’s proprietary research tracks consumer attitudes toward ingredients, nutrition, product claims, and packaging labels. With nearly 14,000 participants across 29 countries in 2025 alone, and over 100,000 interviews conducted over the last ten years, the findings provide a clear picture of what drives purchasing decisions. The research highlights three key areas: top purchase drivers, claims that influence spending, and generational differences in priorities.
Here are some of the highlights from the report, and what they mean for the future of food and beverages.
Consumer’s preferences in food and beverages are not just influenced by the price tag. While cost
remains a key factor in decision making, shoppers are increasingly driven by lifestyle choices, health goals, and personal values.
While price matters to roughly a quarter of shoppers, 45% are motivated by nutrition, ingredients, and wellness when choosing food and beverages. This trend shows that consumers value products that support their health and wellbeing, and they respond to brands that emphasize ingredient quality and nutritional benefits.
Consumers Are Willing to Buy More from Brands Featuring Clean Labels and HealthForward Claims

Consumers consistently associate certain product claims with added value. Labels such as ”natural,” “all-natural,” “organic,” “high protein,”
“no artificial ingredients,” and products that offer health benefits are among the top claims consumers are willing to pay a premium for. Many shoppers, especially younger generations such as Gen Z and Millennials, are willing to spend up to 20–30% more for products with these claims. This willingness enables brands to reformulate products using quality ingredients that help provide functional benefits and better meet consumer expectations.
Consumers are steering away from ingredients they cannot recognize or pronounce. Claims like “simple ingredients,” “short ingredient list,” and “ingredients traceable to source” have grown in importance since 2023. This suggests shoppers are increasingly seeking clean, recognizable, minimally processed products. These preferences are driving innovation in food and beverage brands that recognize the value of simplifying recipes, being transparent about sourcing, and emphasizing ingredient quality on packaging.
Health-focused factors continue to lead purchase decisions. Consumers are not just looking to fill up - they want products that deliver nutrition, support wellness, and align with personal goals. This means food and beverage brands should focus on developing products with functional benefits like high-fiber content, digestive support, or sugar-reduction ingredients. It also means being transparent about ingredient lists and nutrition claims.
Clean label claims influence both purchase decisions and spending thresholds. Consumers are drawn to products that are fresh, natural, and free from artificial ingredients. Simple ingredient lists are particularly appealing, signaling honesty and transparency. Food and beverage brands can leverage this by reducing unnecessary additives, shortening ingredient lists, and clearly highlighting quality on packaging when formulating new products.
While all consumers respond to clean label and health claims, different generations prioritize different benefits. Gen Z places high importance on no artificial ingredients, Millennials prioritize high-protein claims, and Gen X looks for reducedsugar options.
Understanding these nuances allows brands to tailor product messaging and positioning to specific audiences, rather than taking a one-sizefits-all approach.
As consumers show a growing willingness to purchase premium products with health-forward claims, brands gain the confidence to innovate and improve. It creates opportunities for brands to offer more premium products if they emphasize ingredients, nutrition, and wellness benefits. Brands that understand which claims resonate with their target demographic can respond to these opportunities while staying aligned with consumer values.
This article draws from the insights featured in the e-book Feeding Demand: Tracking Consumer Food & Beverage Preferences, which takes a deeper dive into the data and trends shaping today’s consumer choices.

Raymond Deidrick is Vice President & General Manager Texture & Healthcare Solutions ASEAN and Texture Solutions Food Lead APAC. Ray is passionate about driving sustainable solutions that result in positive environmental, commercial, and social outcomes for business and the community.
“Thailand’s journey to balance access, affordability, and quality is ongoing. Through collaboration and policy innovation, the country is moving toward a more equitable healthcare future.”
How is Thailand’s healthcare industry balancing access, affordability, and quality?
Thailand’s healthcare system is a regional model for inclusivity, built on a strong Universal Health Coverage (UHC) framework. Over 75% of the population is covered through the Universal Coverage Scheme (UCS), alongside the Civil Servant Medical Benefit Scheme (CSMBS), and Social Security Scheme (SSS), ensuring broad access to essential services.

However, access to innovative medicines remains uneven. Geographic disparities, complex reimbursement processes, and limited coverage for advanced therapies such as treatments for

rare diseases, oncology, and biologics, continue to pose challenges. Strict Health Technology Assessment (HTA) thresholds and pricing controls further limit availability.
Pfizer Thailand has supported alternative financing models to help improve access to cutting-edge treatments. Yet, affordability remains a concern, with patients often facing high out-of-pocket costs for therapies not covered by national schemes.
Thailand’s journey to balance access, affordability, and quality is ongoing. Through collaboration and policy innovation, the country is moving toward a more equitable healthcare future.
What role does technology play in improving patient experience and care delivery?
Thailand’s healthcare sector is undergoing a digital transformation, with technology reshaping how care is delivered, accessed, and experienced. No longer just a tool for efficiency, digital innovation is now a strategic enabler of patient-centric care. Pfizer Thailand is leading this shift by integrating technology to improve access and outcomes, aiming to ensure every patient, regardless of location, receives timely, personalized, and highquality care.

The Covid-19 pandemic accelerated telemedicine adoption, with innovative platforms enabling remote consultations and expanding access in underserved areas. Artificial Intelligence (AI) is also transforming care by enhancing diagnostics, predicting disease progression, and supporting clinical decisions, helping providers move from reactive to proactive care. As Thailand continues to invest in digital infrastructure, the focus remains on putting patients at the center. Technology is not replacing human care-it is enhancing it.
How can private and public providers collaborate to strengthen the system?
In Thailand, achieving equitable and high-quality healthcare under Universal Health Coverage (UHC) requires more than just service delivery-it demands true collaboration. Public and private sectors must work together through structured partnerships, regulatory alignment, and shared innovation. Strengthening the healthcare system means co-creating policy, integrating technology, and aligning economic incentives.
Trust, accountability, and aligned goals are key to advancing Thailand’s health resilience. Pfizer strongly advocates for multi-sectoral collaboration as a strategic pathway to support Thailand’s evolving health priorities, including UHC, digital transformation, healthy aging, and sustainable financing. This collaborative approach is essential to building a future-ready healthcare system that delivers for all.
“Trust, accountability, and aligned goals are key to advancing Thailand’s health resilience.”
How is the sector preparing for an aging population while promoting prevention?
By 2040, one in three Thais will be aged 60 or older, placing Thailand among the world’s superaged societies. This demographic shift presents both challenges and opportunities, prompting multi-sectoral efforts to ensure aging is met with dignity, health, and empowerment.
The government is promoting health literacy and preventive lifestyles to combat chronic diseases like cancer, diabetes, and other noncommunicable diseases (NCDs). Through education and community engagement, these initiatives aim to reduce long-term healthcare burdens and improve quality of life.

Pfizer Thailand is aligning its strategy with this demographic evolution by expanding access to treatments in oncology, anti-infectives, internal medicine, and vaccines - areas vital to aging
populations. Guided by the pillars of innovation, access, and education, Pfizer is investing in advanced therapies, improving healthcare accessibility, and fostering public understanding of disease prevention. Together, these efforts support a resilient healthcare ecosystem for Thailand’s aging society.
What are the key opportunities and challenges in positioning Thailand as a regional healthcare hub?

Thailand has emerged as a global hub for medical tourism, drawing millions annually with its affordable, high-quality care and internationally accredited hospitals. As the country transitions into an aging society, demand for specialized services, such as geriatrics and chronic disease management is rising. Private hospitals are expanding rapidly,
offering premium care and driving innovation through advanced technologies. However, the sector faces key challenges. A shortage of skilled medical professionals, particularly in specialized fields, threatens long-term growth. Retaining talent and improving training pipelines are critical. Regulatory complexity and slow approval processes can also hinder foreign investment and innovation. While public healthcare remains strong, funding limitations and uneven infrastructure, especially in rural areas persist.
Balancing the growth of medical tourism with equitable access for Thai citizens is essential. As regional competitors like Singapore and Malaysia vie for prominence, Thailand must differentiate through cost-effectiveness, service excellence, and continued innovation.
“Thailand must differentiate through cost-effectiveness, service excellence, and continued innovation.”



Pfizer is reinforcing its commitment to improving health outcomes in Thailand through innovative medicines and vaccines in areas including oncology, internal medicine, vaccines, neurology, and infectious disease prevention. With nearly 70 years of presence in the country, Pfizer continues to partner with government, healthcare professionals, and communities to deliver “Breakthroughs that change patients’ lives.”





Pfizer is investing in next-generation oncology research, including immunotherapy and precision medicine. Through its collaboration with biopharmaceutical company 3SBio, the company is advancing the SSGJ 707 bispecific antibody project, which targets both PD-1 and VEGF proteins, offering a novel approach to more effective cancer treatment. Pfizer holds global rights outside China and plans production in the U.S. The company aims to transform cancer into a manageable condition

Pfizer addresses respiratory infections like pneumococcal pneumonia, RSV, and COVID 19 by advancing vaccines and antiviral treatments. Two new vaccines recently approved in Thailand include a 20 valent pneumococcal vaccine and an RSV vaccine protecting young children and older adults, supporting national health goals and reducing disease burden.





As Thailand’s population continues to age and healthcare needs become increasingly complex, Pfizer remains dedicated to partnering with the government, the medical community, and all sectors of society. The company recognizes that addressing Thailand’s healthcare challenges requires close and continuous collaboration across public, private, and medical stakeholders. Through its ongoing commitment to research and development, Pfizer will continue to bring forward innovative medicines and vaccines, grounded in scientific breakthroughs, to raise standards of care and expand access to meaningful health innovations for all Thais.

By Dr. Atthachai Homhuan and Petcharat Timpuangtong, Tilleke & Gibbins

Thailand has enacted amendments to its alcohol control legislation that tighten restrictions on marketing and advertising, strengthens enforcement, and creates mechanisms to support tourism. The Alcoholic Beverage Control Act (No. 2) B.E. 2568 (2025), published in the Government Gazette on September 9, 2025, will take effect on November 8, 2025.
Key aspects of the new law are outlined below.
Sales-hour restrictions remain in effect, though governed under an updated regulatory framework. Alcohol sales are permitted only between 11 am and 2 pm and between 5 pm and midnight, with exceptions for airport terminals, entertainment venues under the Entertainment Place Act 1966, and hotels. Despite earlier discussions about relaxing these hours, no changes have been implemented under the new law.
Sellers may now check identification cards to verify age and assess intoxicated customers,
with specific conditions to be announced by the Department of Disease Control. Sellers who willfully or negligently violate the law and cause damage to life, health, or property face penalties.
The law allows alcohol sales via vending machines that can verify buyer information and comply with rules, procedures, and conditions to be prescribed by the Alcoholic Beverage Control Committee. This means the industry must await the committee's implementing regulations before deploying such machines.

The amendment broadens the definition of” marketing communication” to include any direct or indirect act of promotion of alcoholic beverages through advertising, public relations, sales promotions, sponsorships, or any other activities that could encourage consumption. This includes using names, trademarks, symbols, or representations associated with alcoholic beverages, regardless of whether the product contains alcohol. The definition is intentionally broad to capture a wide range of activities and communications that could influence consumer behavior.
Key restrictions prohibit:
• Advertising alcoholic beverages, except for providing information, knowledge, or public relations activities subject to ministerial rules.
• Using alcoholic beverage names or trademarks in public communications is intended to induce consumption, except in limited academic contexts. Advertising any product using alcoholic beverage names, trademarks, or symbols in ways that could be understood as alcoholic promotion.
• Sponsoring social or public benefit activities that promote alcohol consumption, subject to further ministerial notification.
These restrictions may extend to products bearing alcoholic beverage trademarks, including nonalcoholic beverages and drinking water, as well as event sponsorships where such use could be perceived as promoting alcohol consumption.
The amendment imposes more stringent penalties for violations. Producers, importers, or sellers who breach advertising and marketing promotion guidelines may face fines of up to 500,000 baht (approximately 15,800 U.S. dollars), with an additional daily fine of up to 50,000 baht (approximately 1,580 U.S. dollars) until compliance is achieved. Enforcement officers may
order closures, notify relevant authorities, and recommend suspension or revocation of licenses under the Excise Tax Act.
The new law represents a significant tightening of Thailand's alcohol control regime, particularly regarding advertising, sales practices, and enforcement. Businesses producing, importing, or selling alcoholic beverages should update compliance programs and monitor forthcoming regulations, especially those affecting advertising and trademark representation in the food, beverage, hotel, and events industries.

Dr. Atthachai Homhuan is director of the regulatory affairs group at Tilleke & Gibbins, where he helps companies in the highly regulated life sciences sector secure patents and achieve compliance.

Petcharat Timpuangtong is a consultant in Tilleke & Gibbins’ regulatory affairs team in Bangkok. She assists businesses with matters pertaining to food, cosmetics, and medical devices.
By Nuttaros Tangprasitti and Maychaya Phoraksa, Nishimura & Asahi

Effective May 31, 2025 (within 30 days of May 1, 2025, the date the Notification was published in the Royal Gazette), Thailand’s Food and Drug Administration (FDA), in collaboration with the Thai Customs Department, implemented the Notification of the Food and Drug Administration Re: Control of Health Products Listed in the Customs Department's Controlled Goods Database, B.E. 2568 (2025) (Notification), a new regulatory framework that will govern health products listed in the Customs Department’s Controlled Goods Database via the Thailand National Single Window (Thai NSW) system. The initiative is part of the Thai government's broader strategy to modernize trade and strengthen public health protections through integrated digital systems.
The Notification represents a significant step toward enhancing cooperation between two key regulatory bodies - the FDA and the Customs Department with an intent to streamline compliance procedures, eliminate duplication, and improve the accuracy of product verification during the import and export process.
The Notification applies to a comprehensive range of health products under FDA supervision and listed in the Controlled Goods Database, including pharmaceuticals, medical devices, food and dietary supplements, cosmetics, herbal products, and hazardous substances for consumer and industrial use.
Traders dealing with these items must comply with the updated procedures under the new system.
To ensure clarity, the Notification provides key definitions, including:
• Health Products: Products listed in the Customs Department’s Controlled Goods Database that are regulated under FDA-administered laws, including medicines, food, medical equipment, cosmetics, narcotics, psychotropic substances, hazardous household items, and herbs.
• Government Authorities: The FDA or any agency designated by the FDA to issue approvals or supporting documents, in electronic or physical form, for import or export purposes.
• Customs Tariff Code and Statistical Code: The eight-digit product classification code (comprised of Chapter, Heading, and Subheading), and the three-digit statistical code, as established by the Thai Customs Department.
• List of Goods: The names and descriptions of products, categorized under the relevant customs tariff codes and statistical codes.
• Permit: A license or certificate required under applicable laws (for example, Drug Act, Food Act, Hazardous Substances Act) before import or export is permitted.
• License per Invoice (LPI): A document issued by the FDA in connection with the importation of health products, intended for electronic data linkage. It serves as a notice of importation into the Kingdom of Thailand but is not considered a legal permit under FDA-administered laws.
• Importer/Exporter: Any person or entity that imports or exports health products and is responsible for ensuring accurate declarations and compliances with all relevant laws.
• Connection of Electronic Information: The data link between the government and/or private electronic systems for import/export, through THAI NSW.
• Controlled Goods Database: The Customs Department database of goods subject to control by various government agencies, including FDA-regulated health products.
Check whether the product is listed in the Controlled Goods Database published by the Thai Customs Department on their website. Only
products under FDA supervision and listed with the proper Customs Tariff Code and Statistical Code require permits and electronic submissions.
Before applying for an import permit, the importer must submit product information through the THAI NSW - a centralized platform for electronic data submission and inter-agency coordination.
• The importer must record the List of Goods on the invoice accurately and ensure that all items are FDA- regulated health products.
• The importer must obtain a License per Invoice (LPI) from the FDA. The LPI is a notification, not a permit, and is electronically linked to the customs system.
Once the LPI is received:
• The importer must enter the Permit Number and LPI into the Import/Export Declaration Detail (Permit) form.
• This information is transmitted to the Customs Department electronically, to generate a customs declaration and proceed with clearance.
If a product is listed in the Controlled Goods Database and falls within FDA regulation, it must be accompanied by a valid Permit (such as a license under the Drug Act, Food Act, or Hazardous Substances Act). The permit must be linked to Customs electronically through THAI NSW.
If the importing Government Authority cannot transmit the LPI electronically (for example, due to a system error or agency limitations), the FDA may allow customs clearance based on paper documents on a temporary, case-specific basis.
Exemptions
(Notification, Clauses 8 to 11)
Certain low-risk or special-purpose imports, for example, research tools, spare parts, goods licensed by other agencies, or those with prior FDA approval, are exempt from license submission requirements.
If a Government Authority issues rules requiring importers or exporters to follow procedures different from those in the Notification, such procedures must ensure that the health products listed in the Controlled Goods Database are properly, efficiently, and legally monitored. Importers or exporters must comply with the those specified procedures.
Businesses importing or exporting health-related products must align their operations with the new FDA regulations via integration with the THAI NSW. This includes accurately identifying whether products fall under FDA supervision and ensuring correct use of Customs Tariff Codes and Statistical Codes.
Importers must obtain an LPI for every shipment of health products, even though it is not a formal permit. The LPI must be electronically linked to customs declarations. Where a formal permit is required (for example, under the Drug Act or Food Act), it also must be linked to the customs system properly to avoid clearance delays.
The regulations provide for several categories of exemptions that may relieve businesses of certain documentation requirements in low-risk or special cases. Importers must understand the scope and conditions of each exemption and be prepared to submit supporting documents where needed.
In exceptional situations, such as system failures or where special procedures are mandated by other government authorities, businesses must be ready to follow temporary or alternative procedures, which may include manual (paper-
based) submissions. Companies should establish internal compliance protocols, train staff, and maintain thorough records to ensure smooth customs clearance and regulatory compliance.


Nuttaros Tangprasitti is a Partner at SCL Nishimura & Asahi in Corporate and Commercial practice group, advises on M&A, joint ventures, foreign investment as well as all kinds of legal compliance, bringing more than 15 years of experience in corporate and commercial matters, banking and finance, legal compliance and visas and immigration matters.

Maychaya Phoraksa is an Associate at at SCL Nishimura & Asahi in Corporate and Commercial practice group with experience in M&A, joint ventures, crossborder investment, corporate governance, real estate, and legal compliance.

Dear Members,
The new government took office on October 1, 2025. As AMCHAM adapts to this change, we are adjusting our advocacy plans to align with the new administration's policy priorities. We have sent congratulatory letters to key government ministries, including Commerce, Finance, and Digital Economy and Society, among others, as well as requested roundtable meetings with them.
As a part of our ongoing efforts to offer member resources and expertise to the government, we recently conducted our first capacity-building workshop on Transfer Pricing with over 70 customs department officials. This initiative stemmed from our engagement with the Director-General of the Customs Department, where we offered our members' expertise to help officials better understand business practices. The workshop was highly successful, and other councils are now exploring similar opportunities with different agencies.
Through our council leadership, we submitted four recommendation letters this month: the Government Affairs Council's recommendations on managing foreigner taxes, visa and residency services, and immigration-related matters; the Food & Agribusiness Council's recommendations on criteria, method, and conditions for ad-valorem beverage tax payment; joint recommendations from the Government Affairs and Digital Economy Councils on TCCT's draft guidelines for unfair trade practices in e-commerce; and Tax Council's recommendations on Qualified Refundable Tax Credits (QRTC) to support the Board of Investment’s (BOI) discussions with the Revenue Department and the Office of the Council of State. These letters can be found in the AMCHAM Member Info Center In other developments, the ESG Council is preparing recommendations on B-READY's Utilities assessment and the draft Clean Air Act. The Healthcare Council is gathering member feedback on B-READY's Market Competition

assessment, while the Customs & Excise Council is refining a recommendation letter on Counterfeit and Illicit Goods. These papers will be discussed at their respective council meetings. All members are invited to participate in any council or committee meeting.
Our Government Affairs team continues to build and maintain meaningful relationships with relevant ministers and government agencies, who remain enthusiastic about engaging with AMCHAM. We stand ready to provide feedback on behalf of our members and collaborate with the government to improve Thailand's economy and ease of doing business.
Jen Meckhayai Government Affairs Director
Including Ford Care Program 5-Year or 150,00 km
Factory Warranty (whichever comes first)


On September 26, the AMCHAM Customs and Excise and Tax Councils organized a comprehensive Transfer Pricing Workshop in collaboration with the Customs Department. This exclusive, trailblazing capacity-building session brought together approximately 70 officials from the Customs Standard Procedures and Valuation Division, Legal Affairs Division, and Post-Clearance Audit Division, marking a new approach to AMCHAM advocacy.
The workshop covered crucial aspects of transfer pricing and its intersection with customs valuation. It began with an in-depth introduction to transfer pricing concepts and methodologies, and a significant portion was dedicated to sharing best practices from other countries and the World Customs Organization (WCO) guidelines.
The workshop concluded with a set of actionable recommendations presented to the Customs Department, aimed at enhancing their understanding and application of transfer pricing principles in customs valuation. Throughout the event, attendees engaged in dynamic discussions, fostering a collaborative environment for knowledge exchange. This workshop not only advocated for AMCHAM members but also contributed significantly to building capacity within the department on this crucial issue for cross-border trade.




On October 1, AMCHAM Vice President Ornkanya (Mook) Pibuldham of Bank of America led an AMCHAM delegation to a working meeting with the Board of Investment (BOI) team. The meeting focused on the Draft Competitiveness Enhancement Act and Qualified Refundable Tax Credits (QRTC).
In light of recent amendments to the Competitive Enhancement in Targeted Industries Act, particularly regarding QRTC, AMCHAM sought to understand the plans and processes for implementing the draft Act on QRTC. The meeting allowed both parties to discuss the implications of the new legislation and potential collaborations to ensure its pragmatic implementation, supporting Thailand's economic objectives and maintaining its attractiveness to foreign investors.
AMCHAM reiterated its stance as a long-term partner, ready to assist the Thai Government in enhancing ease of doing business and attracting foreign direct investment. The delegation looked forward to a productive exchange of ideas and exploring ways to contribute to Thailand's continued economic growth.




On October 14, AMCHAM President Chatit Huayhongtong of Chevron led a delegation, including AMCHAM Vice Presidents Ornkanya Pibuldham of Bank of America and Wiyada Srinaganad of 3M Thailand, to meet with Secretary General Dr. Chula Sukmanop and Assistant Secretary General Dr. Cholachit Vorawongso Virakul.
Dr. Chula provided updates on the EEC, noting that the U.S. is among the region’s top five investors. Digital investment has grown to account for more than 40%. The EEC recently launched its new development plan, EECiti strategically located within 15 km of major EEC industrial estate promotional zones and Map Ta Phut port, and within 30 km of Pattaya and other tourist attractions. EECiti aims to attract a highly skilled foreign workforce, establish a medical hub, and host international universities.
Dr. Cholachit shared insights from her recent visit to the U.S., focusing on the semiconductor and medical technology industries. Some feedback from U.S. companies included concerns around adequate supply for green energy and transshipment issues.
AMCHAM delegates shared feedback about member companies in the EEC area and the AMCHAM Scholarship Program, which recently launched support for vocational students. AMCHAM also offered its member companies as resources to support EEC development and attract new investors.
Weerawat Meekaew is the Government Affairs Director at Johnson & Johnson Thailand and serves as an AMCHAM Healthcare Council Co-Chair.

What are your goals for the Healthcare Council this year?
As Co-Chair, my key goal is to showcase the value of healthcare innovations and their impact on Thailand’s healthcare system through close collaboration with stakeholders.
Focusing on a sustainable healthcare financing roadmap as this year’s main priority, we aim to address the rising burden of noncommunicable diseases (NCDs) and the issues related to an aging population. A well-planned roadmap will secure funding for innovative medical solutions, support universal coverage, reduce financial hardship, and provide Thai patients with access to the latest medical innovations for a better quality of life.
From your perspective, what makes Thailand’s healthcare sector unique?
Thailand is uniquely positioned as a regional medical hub, supported by strong government
policies. The country’s high number of JCI-accredited hospitals and qualified healthcare professionals (HCPs) ready for clinical trials reflect its commitment to global healthcare standards.
Clinical research plays a key role in driving innovation, boosting GDP, improving health outcomes, and creating high-skilled jobs. Every baht invested yields significant returns for both the economy and patients. However, challenges such as regulatory delays, limited funding, lack of collaboration, and outdated data systems remain. Addressing these issues requires collective action among government, industry, academia, and healthcare providers.
What inspired you to get involved in healthcare advocacy through AMCHAM?
I am driven by a strong belief in putting patients at the heart of everything I do. When we succeed in shaping policies that improve access, affordability, and innovation, the real beneficiaries are Thai people and communities.
Being part of AMCHAM gives me the chance to work with leaders and organizations who are committed to this shared vision. It is a platform to shape policies with real impact, ensuring innovation reaches those who need it most and strengthening Thailand’s position as a healthcare leader in the region.


A soon-to-be pharmacist with a passion for bridging the gap between science and patient care. Jakarat is on a mission to turn knowledge into compassion, making sure patients do not just get prescriptions but they get understanding.

Hello, T-AB Magazine readers! I am currently a sixth-year student at the Faculty of Pharmacy, Srinakharinwirot University, majoring in Industrial Pharmacy. I am completing my internship in Regulatory Affairs at Zuellig Pharma and will soon begin my next internship as a Patient Journey Partner at Roche.
My journey has not been easy. My family runs a small street business, and I have helped since I was young. When our shop was forced to relocate and eventually reduced to a street stall, our income declined. The Covid-19 pandemic made things even harder. These experiences taught me to value every Baht and to live with gratitude and resilience. Although I have never been a “top student,” I have always worked hard and made the most of every opportunity.
I applied for the AMCHAM Scholarship to ease my family’s financial burden and to save up
“The AMCHAM Scholarship doesn’t just support our education, but it also gives students like us the opportunity and motivation to follow our dreams.”
for an iPad that would help me learn during online classes. What led me to AMCHAM was a professor’s recommendation and the inspiration I found while exploring the website. It became clear that AMCHAM is more than just financial support; it is about community, growth, and giving back.
Receiving the scholarship helped me focus on my studies without worrying about expenses. It also gave me the confidence to dream bigger—to one day become a knowledgeable and compassionate medical representative, someone who can bridge the gap between science and patient care.
Although I could not attend the Career Camp due to my internship, I did join the Orientation Camp. It was an incredible experience: fun, educational, and full of warmth. From CPR workshops to financial planning, and from shy introductions to lasting friendships, it gave me both skills and confidence. The workshops and mentoring from AMCHAM helped me develop important soft skills such as communication, presentation, and adaptability. These are the skills I now use every day during my internship. I have come to realize that being a pharmacist is not only about having knowledge but also about being curious, detailoriented, and empathetic.
With all my heart, thank you, AMCHAM, for believing in students like me. I hope that one day I will be able to give back by helping and inspiring others, just as I have been helped and inspired.


Education has been a core value for AMCHAM since the very beginning of the Chamber. Over the last three decades, AMCHAM has provided over 3,200 scholarships and supported over 890 primary schools.
In 2004, AMCHAM formally registered the American Chamber of Commerce in Thailand Foundation (ATF) to carry out its charitable activities. The ATF is recognized by the Ministry of finance as a Public Charitable Organization (number 632) and donations are deductible in Thailand.
Each year ATF enables disadvantaged Thai university and vocational students to complete their higher education studies through targeted scholarships. Our Community Engagement Council works directly with universities and vocational colleges to identify hard-working and motivated students enrolled in programs championed by AMCHAM member companies.
Sponsor university scholarship. Provide speakers and goodie bag items for Orientation/Career. Join the Community Projects Council. For further information, contact foundation@amchamthailand.com.


On September 19, 2025, the American Chamber of Commerce in Thailand (AMCHAM) hosted its annual AMCHAM ChariTee Golf Tournament at the Alpine Golf Club, bringing together the international business community for a day of fun and philanthropy. The event raised over one million baht to support the American Chamber of Commerce in Thailand Foundation (ATF). The funds will go towards providing educational scholarships for Thai university students across the country.
“The AMCHAM ChariTee Golf Tournament is more than a fundraiser – it is a cornerstone event that generates crucial funds for our scholarship program while bringing the AMCHAM community together in a spirit of unity and purpose,” said Heidi Gallant, AMCHAM Executive Director and Vice President of the ATF. “The participation and support of our members underscore the international business community’s dedication to investing in Thailand’s future workforce.”
Beyond its charitable contributions, the tournament gave AMCHAM member executives and the broader business community a chance to connect and strengthen relationships. On one of Thailand’s premier golf courses, participants enjoyed friendly competition while making a lasting impact on the lives of students.
This annual event was made possible by the generous support of sponsors, including AGS Four Winds International Moving, AIG Insurance, Alpine Golf and Sports Club, Amazon Web Services, Avis International Car Rental, BECIS, Boon Rawd Brewery, Chevron, C.P. Group, Coca-Cola, Constant Energy, Diageo Moet Hennessy, ELC International Schools Bangkok, EVA Air, Ford Motor Company, Lawton Asia, Mastercard, mentabuild, Netflix, Pacific Prime Consultants, Phyathai Hospital Group, RMA Group, Topgolf Megacity, TOS Group, Royal Orchid Sheraton Riverside Hotel Bangkok, and United Airlines. All proceeds from the event will directly benefit the ATF scholarship program, which provides financial assistance to high-achieving Thai university students from disadvantaged backgrounds.
The AMCHAM ChariTee Golf Tournament highlights the generosity of the international business community but underscores the value of investing in education as a pathway to a stronger, more prosperous Thailand.























Speaker: Arkkapat Varnapruk of Department of Trade Negotiations
Moderator: Simonetta Verdi of Ford Motor Company
Organized by: Auto Council
Event Highlights:
AMCHAM Auto Council welcomed Arkkapat Varnapruk, Chief of the Industrial Section, Bureau of Trade in Goods, Department of Trade Negotiations, for an informative session on how the ThaiEU Free Trade Agreement is reshaping Thailand’s automotive industry. The speaker outlined the Thailand-EU automotive trade landscape, trade rules, and barriers that must be addressed for the agreement to succeed. Participants raised questions on rules of origin in the automotive industry, the possibility of EU-FTA being completed by 2025, and compliance with the Carbon Border Adjustment Mechanism (CBAM).



Event Highlights:
AMCHAM hosted a networking member luncheon at Park Hyatt Bangkok to launch the AMCHAM Board Election season. At the event, candidates introduced themselves and their goals. Members had the opportunity to connect with both current and future leaders of the AMCHAM business community.
The candidates running for the 2026-2027 term are:
• Sasathorn Phaspinyo of FedEx Thailand
• Anothai Wettayakorn of IBM Thailand
• Charles Blocker of IC Partners
• Dilip Kumar Agarwal of Indorama Ventures
• Raymond Deidrick of Ingredion
• Jonathan Powell of Jelly Belly Candy Company
• Naambo Shivute De Cock of LawtonAsia Insurance Brokers
• Prae Dumrongmongcolgul of Meta
• Ririnda Tangtatswas of Minor International
• Idara Huang of Mondelez International
• Jacob Holder of The Mobius Agency (TMA)
• Frank Timmons of Tractus Thailand
• Paul Uthaichalanond of Vantive Healthcare
• Philip Bernard of Western Digital
Learn more about our candidates here



Joint Commitee and Council
Moderator: Kulnisha Srimontien of PriceSanond
Organized by: Digital Economy Committee and Government Affairs Council
Event Highlights:
The AMCHAM Digital Economy Committee and Government Affairs Council convened a working meeting to discuss the Trade Competition Commission of Thailand’s (TCCT) Draft Guidelines on Unfair Trade Practices and Anti-competitive Conduct on Digital Platforms for the Sale of Goods or Services (e-commerce). Members exchanged insights on key regulatory developments shaping Thailand’s digital economy, including practices from European countries, Over-the-Top (OTT) regulations, Draft Platform Digital Economy Act, National AI Policy, and Digital Service Tax.

Council
Speaker: Akrim Jantaraprapa of IQVIA Thailand
Moderator: Weerawat Meekaew of Johnson & Johnson
Organized by: Healthcare Council
Event Highlights:
The AMCHAM Healthcare Council hosted an exclusive video conference for an in-depth discussion on the latest U.S. tariffs and their implications for the global, regional, and Thai healthcare landscape. The speaker provided analytical perspectives on the 19% tariff’s impact on Thailand’s healthcare sector and highlighted the risks and opportunities in the shifting global environment. Participants also engaged in a question-and-answer session, exchanging insights and exploring strategic responses shaping the industry’s path forward.



Speakers: Neil Martin Russell of Bangkok Silicon Solutions and Dusita Khanijou of Tilleke & Gibbins
Moderator: Naambo Shivute of LawtonAsia
Organized by: Human Capital Committee and Inclusion Committee
Event Highlights:
The Breaking Barriers – Recognizing Discrimination and Transforming the Thai Workplace event featured insights and conversations on the subtle barriers that shape workplace experiences in Thailand. Discussions highlighted how unconscious bias continues to affect women, older workers, LGBTQ+ individuals, and people with disabilities. Proposed solutions emphasized the importance of pay audits, inclusive hiring practices, training, accessible workplaces, and stronger reporting systems.
The event underscored that beyond written policies, daily practice and genuine inclusion are essential to building a fair, innovative, and high-performing workplace.




Speakers: Suruswadee Jaimsuwan of Tilleke & Gibbins and Chai Lertvittayachaikul of Kudun & Partners
Moderator: Jackson Pek of Amadeus Asia
Organized by: Legal Committee
Event Highlights:
The AMCHAM Legal Committee hosted a panel discussion on Thailand’s evolving legal landscape. Speakers explored how recent and upcoming legal developments are reshaping the business environment. Topics included amendments to the Foreign Business Act, potential ESG legislation, HR and employment issues, the Employee Welfare Fund, and new parental leave regulations. Participants also exchanged perspectives in a dynamic question-and-answer session, sharing perspectives on turning regulatory shifts into opportunities for stronger business governance.







Hosts: Wiyada Srinaganand of 3M Thailand; Sondra Sutton Phung of Ford Motor Company; Simon Denye of Harmless Harvest; Winnie Wong of Mastercard; Prae Dumrongmongcolgul of Meta; and Philip Bernard of Western Digital
Event Highlights:
AMCHAM hosted the Governors’ Table, which brought together leading business executives to foster valuable connections at The St. Regis Bangkok. Guests enjoyed an exclusive dinner accompanied by panoramic views of the Bangkok Sports Club and city skyline.







Council
Speakers: Rick Hilchner of Bosch Automotive Thailand (RBTA); AJ Dabydin of Carrier Thailand; and Sutheep Ratnabhas of Maxion Wheels
Moderator: Jeff Fertuck of Crossover Solutions
Organized by: Auto Council
Event Highlights:
AMCHAM Auto Council held a panel discussion, exploring how Thailand’s automotive suppliers are adapting their sourcing, pricing, and production strategies to survive and thrive in today’s challenging trade and market realities. The discussion covered manufacturing initiatives in response to current conditions, business strategies amid market volatility, challenges within the supply base, and key operational changes across the industry.






Event Highlights:
AMCHAM, in partnership with AustCham, BCCT, BeLuThai, CanCham, FTCC, GTCC, ITCC, NTCC, SATCC, and STCC, hosted a Multi-Chamber EEC Networking event at Hilton Pattaya. Business professionals and entrepreneurs from various industries expanded their networks, gained valuable insights, and enjoyed the stunning sea view, a perfect way to spend a Friday night.






By Cargill

• Every day, more than one billion meals are lost to food waste. That is nearly 30% of all the food produced globally.
• From recovering more meat during processing to extending shelf life, and even turning chocolates into feed, Cargill is innovating to waste less and nourish more.
Seeing What the Eye Cannot: More Meat, Less Waste
In a meat processing plant in Friona, Texas, and others like it, workers trim meat every day. Even the most skilled hands can miss what technology can now catch and save.
That is where CarVe comes in, Cargill’s proprietary patent-pending technology. CarVe uses computer vision to measure red meat yield in real time, giving frontline managers instant insights and the ability to share feedback with employees to improve their technique.
This keeps more protein in the food system that otherwise would be lost in the process. According to the USDA Economic Research Service, the U.S.
produces more than 27 billion pounds of beef annually. Even a one percent improvement can save hundreds of millions of pounds of meat.
“Before CarVe, yield data was always yesterday’s news,” says Leon Fletcher, an operations leader for Cargill. “Now, we are making decisions in the moment and saving product that would have been lost.”
With the U.S. cattle supply at its lowest level in years, improving yield matters more than ever. CarVe is just one way Cargill is applying smart technology to maximize every animal, reduce waste, and make protein production more efficient and sustainable from start to finish.
“People buy with their eyes,” says Anna Snow, a research and development leader at Cargill. “If food does not look fresh, it often does not get a second chance even when it is perfectly safe.”
That is why Cargill Natural Flavors was developed to address a common shopper misconception: that gray coloring on ground beef means it is spoiled.

Ground beef naturally loses its red color over time due to oxidation, caused by exposure to light and air. For many consumers, color is a key indicator of
freshness. As the color fades, so does the chance of a sale - often leading retailers to discard safe, high-quality meat.
Cargill Natural Flavors is a proprietary blend of natural antioxidants that slows oxidation. It helps meat retain its red color and fresh flavor safely for up to five additional days, keeping quality meat on store shelves and family tables longer.
“By extending shelf life, we are not just helping products stay on the shelf longer, we are reducing waste and making the most of the resources it took to produce that food in the first place,” Anna says.
So far, Cargill Natural Flavors has helped preserve more than one and half million pounds of ground beef, with expansions underway to include patties and whole muscle cuts.
What does not make it into candy wrappers at Hershey now helps feed livestock, thanks to a long-standing partnership with Cargill.
At Cargill’s Chambersburg, Pennsylvania facility, surplus chocolate and candy are upcycled into
“candy meal,” a high-energy, nutrient-rich feed for cows, pigs, and other animals. The process removes packaging, recycles materials and blends the rest into a safe, effective feed ingredient. To date, the effort has repurposed around 130,000 tons of candy waste.
It is one more way Cargill is reducing waste, supporting farmers and creating value from what once went unused.

Click here to register

BHIRAJ BURI GROUP, a real estate developer in Thailand, has partnered with Bio Buddy, a food technology and innovation company, to launch Thailand's first Future Food Hub on the 45th floor of Bhiraj Tower at IVORY SHADOW. The Future Food Hub will serve as a center for learning and development and driving innovation in sustainable future food. It will feature exhibitions on food technologies, seminars, workshops, and provide a platform for collaboration between entrepreneurs, researchers, and consumers to support an environmentally responsible food system.
The project is supported by partners such as SOCO WORK and TasteBud. SOCO WORK will provide space for food entrepreneurs and startups to collaborate and develop new products.
The launch of the Future Food Hub marks a significant step in driving Thailand’s role in future food within the ASEAN region and highlights the commitment of BHIRAJ BURI GROUP and Bio Buddy to creating a better future for everyone.


Minor Food has announced a five-year strategy under the theme ‘Passion for Growth’, outlining plans for expansion through 2029. The company is prioritizing franchising as part of an asset-light model and has launched a new brand: The STEAK & MORE.
Thunyachate Ekvetchavit, Chief Development Officer at the Minor Food Group, stated, “The food and beverage sector in Thailand and globally is undergoing a period of recovery and renewed
expansion, while consumer behavior continues to evolve rapidly. Businesses must remain agile in adapting to this changing landscape. Minor Food is setting the course for sustainable organizational growth from 2025 to 2029. The core focus is to strengthen the business model by collaborating with franchise partners in high-potential markets around the world, aiming to boost investment efficiency and overall returns. At present, Minor Food’s portfolio comprises over 30 brands and more than 2,700 outlets in 24 countries, including 1,300 franchised outlets, which account for 48% of total operations— demonstrating strong prospects for future franchisedriven expansion.”
Minor Food will implement its expansion strategy through three key pillars: Expanding franchise brands in Thailand, accelerating international expansion in countries such as Indonesia, and the developing new brands aligned with fast-growing food trends.


MedPark Hospital recently launched its Hair Restoration Center. Prof. Dr. Sinn Anuras, Hospital Director, remarked that the opening of this Center
marks another significant milestone for MedPark in enhancing patients’ quality of life and restoring self-confidence.
Dr. Pongpat Patanavanich, Managing Director of MedPark Hospital, added, “With Dr. Damkerng Pathomvanich assuming the role of Head of the Hair Restoration Center, we are establishing a hospitalgrade standard for safe hair transplantation. This also creates opportunities for individuals with certain health limitations to undergo a hair transplant with greater safety and confidence.”
The Hair Restoration Center aims to provide a trusted and reliable option for individuals experiencing hair loss.
NIST International School celebrates its graduating Class of 2025, whose record-breaking International Baccalaureate (IB) results and university acceptances around the world exemplify academic excellence, global citizenship, and a readiness to lead in an ever-changing world.
The Class of 2025 achieved outstanding IB results, with two students earning a perfect score of 45, a class average of 37, and 27% of the cohort achieving 40 points or higher. Over half of the graduates (56%) earned the Bilingual IB Diploma, and the class achieved a 100% pass rate for the second consecutive year.
The U.S. remains a leading destination for NIST graduates. Members of the Class of 2025 have earned places at Brown University, Cornell University, Carnegie Mellon University, Georgetown University, and the University of California Dr James Dalziel, Head of School,
expressed immense pride in the graduates: “The Class of 2025 has embraced every opportunity to learn, lead, and contribute during their time at NIST. Their achievements speak to their curiosity, courage, and compassion. As they step into this next chapter, they carry not only the academic skills but also the values of service, integrity, and global mindedness that will guide them in shaping a better future.”















Park Hyatt Bangkok has announced the appointment of Chef Alessio Banchero as the new Chef de Cuisine at Embassy Room La Marina, the hotel’s Coastal Italian restaurant. Originally from Genoa, Italy, Chef Alessio brings over two decades of culinary expertise to elevate the dining experience at Embassy Room La Marina, which now unveils a new culinary concept celebrating the vibrant flavors of Coastal Italy alongside beloved everyday Italian favorites.
Renowned for his mastery of coastal Italian flavors, Chef Alessio specializes in Italian classics, bringing
a deep appreciation for traditional recipes across Italy’s rich culinary heritage. His signature dishes reflect the flavors of his hometown.
Chef Alessio said, “Working alongside Chef Daniel Masters and the talented team, I am eager to create unforgettable dining experiences with dishes that resonate with Thai diners’ love for bold, fresh flavors.”

Cathay Pacific has announced the return of its nonstop flights from Hong Kong to Seattle beginning March 30, 2026, reconnecting Hong Kong with the West Coast of the United States. Seattle will be the airline’s ninth passenger destination in North America.
In April 2025, Cathay Pacific debuted its direct passenger flights between Hong Kong and DallasFort Worth, which will increase from the current four return flights per week to daily from October 26, 2025.
The new five-times-weekly service complements Cathay Pacific’s North America summer schedule
for 2026, which includes more than 110 return flights per week to Boston, Chicago, Dallas-Fort Worth, Los Angeles, New York, San Francisco, Seattle, Toronto and Vancouver.




A global leader in revolutionary PFAS-free surface coating protection technology, the company safeguards a variety of materials from water damage and harsh environmental conditions. Specializing in automotive electronics, consumer and industrial electronics, and medical electronics, its thin-film coatings, called Advanced nanoGUARD, can be applied to the entire PCBA, including connectors, antennas, LEDs, and high-heat generating components, while providing up to IPX8 protection levels.
Dulwich College Bangkok provides holistic education for students aged three–18. Following the English National Curriculum, students progress to IGCSEs before choosing either the IB Diploma or A Levels, preparing them for leading universities worldwide. Drawing on Dulwich College London’s 400-year heritage and combining it with innovative teaching and technology, the school delivers an education that honors tradition while embracing the future.
Headquartered in Bangkok with regional offices in Singapore, Giant Pumpkin specializes in digital signage, retail audio streaming, and Digital Out-of-Home (DOOH) solutions across Southeast Asia. The company provides end-to-end services in retail media, property signage, and creative content production, delivering innovative, cloud-based platforms and design, positioning itself as a technology-driven agency offering comprehensive retail and DOOH media services throughout ASEAN.
J.S.T. Services, based in Bangkok, has provided specialized engineering and technical services across Thailand and Southeast Asia for over 40 years. With expertise in asset integrity management, heat treatment, CAD design, property leasing, marine solutions, inspections, and advanced coatings, the company operates under ISO 9001, ISO 14001, and ISO 45001 standards, serving industries from oil and gas to renewable energy with reliable, tailored support and a strong commitment to safety.
A global leader in infant and children’s nutrition, founded more than 120 years ago and headquartered in Evansville, Indiana, USA. Since its inception, the company has been dedicated to earning the trust of parents and healthcare professionals by providing scientifically proven nutritional products that support early childhood development. Backed by the passion and expertise of approximately 5,000 employees, Mead Johnson manufactures and markets over 70 products in more than 50 countries, with major production facilities across every region of operation.
MKS Inc. (NASDAQ: MKSI) provides foundational technology solutions for semiconductor manufacturing, electronics packaging, and specialty industrial applications. With expertise in science and engineering, they deliver instruments, subsystems, process control solutions, and specialty chemicals that enhance performance, productivity, and innovation. Its technologies address the challenges of miniaturization and complexity in advanced device manufacturing while meeting growing performance demands across industrial markets worldwide.
NYA LATAM provides advanced humidity control solutions to protect products across industries, including pharmaceuticals, electronics, textiles, and agriculture. Operating in Panama and the U.S., the company offers desiccant products such as Pillow Packs, Strip Packs, and Integra Boost™ and Integra Dry™ solutions. Biodegradable, non-toxic, and FDA-compliant, NYA LATAM combines innovative, hands-free, bidirectional humidity control with global collaboration to ensure reliable protection while preserving product quality and longevity.
Orbix is one of Thailand’s leading cryptocurrency exchanges and a digital asset trading center operating to international service and security standards. Committed to legal, reliable, and efficient operations, Orbix continuously develops its services to ensure client satisfaction, facilitate seamless daily transactions, and provide essential information on digital asset characteristics, returns, and risks, empowering clients to make informed investment decisions while positioning itself as a trusted leader in Thailand’s digital asset market.
A nonprofit organization dedicated to ending sex trafficking and child exploitation worldwide. Since 2013, they have partnered with law enforcement, governments, and communities to rescue victims, pursue justice, and provide long-term survivor support. They operate across the globe and deliver end-toend solutions, such as intelligence gathering, digital forensics, K9 deployments, and trauma-informed care, while also focusing on education and prevention. Committed to transparency, Our Rescue ensures donations directly support life-saving efforts, empowering survivors with safety, healing, and hope.

SAMS is a line maintenance service partner providing complete peace of mind for airlines and aircraft owners. With principals and engineers from leading carriers and engineering firms, SAMS combines industry expertise with the latest technology, professional standards, and reliability to ensure compliance with corporate, international, and local safety requirements. Leveraging diverse backgrounds and independent thinking, the team delivers innovative solutions that help clients achieve operational excellence and set their business apart.



Solismatica is a boutique AI integration consultancy specializing in ethical, empathetic, and culturally attuned AI solutions tailored for SEA markets. They bridge cutting-edge global AI technologies with local business and government contexts, helping mid-size enterprises and public agencies adopt AI to solve real-world challenges. Their expertise spans healthcare, hospitality, and public sector innovation. By combining deep AI knowledge with a personalized, client-focused approach, Solismatica accelerates digital transformation and sustainable growth for organizations seeking trusted regional AI partnerships.
A leading plastic injection molding manufacturer in Thailand, delivering highquality OEM/ODM solutions across automotive, electronics, home appliances, industrial equipment, and consumer products. With decades of experience, the company provides end-to-end services - from product design and mold fabrication to full-scale manufacturing and assembly. Leveraging advanced technology and a skilled workforce, TechnoPLAS ensures precise, flexible, and cost-effective solutions that consistently meet international standards and client expectations.

The Lotus Azure is a premium, internationally accredited medical diagnostics and wellness center in Bangkok, Thailand, offering pre-departure medical exams for GCC countries, expat and local health screenings, preventive diagnostics, immunology, and outsourced Covid-19 testing. Authorized by the GCC Health Council, Thailand’s Ministry of Public Health, and NHSO-approved, the center operates with precision, compassion, and integrity, delivering a trusted healthcare ecosystem guided by its philosophy: Protect. Preserve. Prosper.

Visteon is a global leader in automotive cockpit electronics, pioneering the software-defined future of mobility through innovative technology solutions. Its comprehensive portfolio spans digital cockpit solutions, advanced displays, battery management systems, and power electronics for EVs, enhanced by cutting-edge software capabilities and artificial intelligence integration.
Corporate Membership is available to all companies registered in Thailand. If you are interested in joining AMCHAM Community, please contact us at membership@amchamthailand.com.







The Chamber is always seeking member submissions for ThaiAmerican Business (T-AB) magazine as well as the AMCHAM website.
Articles should be shared in an editable format accompanied and with any applicable graphics that are 300dpi minimum
Check with the communications team to learn about the theme for our next issue AMCHAM also looks for legal and regulatory developments, knowledge sharing and best practices
Articles should be on topics of general interest with original research or analysis Articles should not be self-promotional or be company member news.
Authors are frequently approached regarding their expertise Be sure to include an author photo and short biography with article submissions.
Please send your article submission for consideration to the communications team before the beginning of the previous month at comm@amchamthailand com